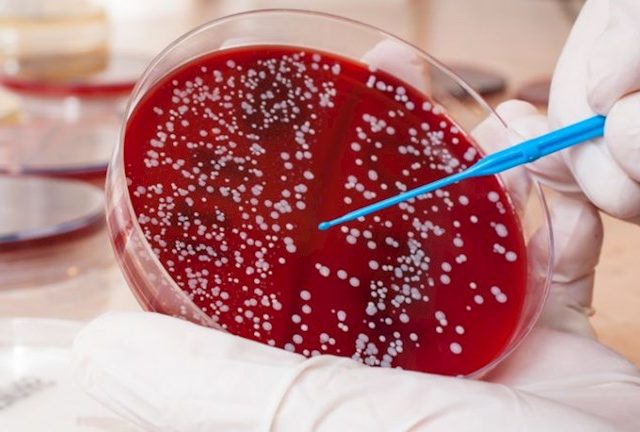
stafylokokos

Ωράριο Ιατρείων
- Δευτέρα – Παρασκευή08:30 - 21:30
- Σάββατο - ΚυριακήΚατόπιν ραντεβού
- Για την καλύτερη εξυπηρέτησή σας, τα ιατρεία λειτουργούν κατόπιν ραντεβού.
Έκτακτα Περιστατικά
Για επείγοντα ή έκτακτα περιστατικά, μπορείτε να επικοινωνήσετε άμεσα μαζί μας.
Έκτακτα Περιστατικά
6909843496
ΧΕΙΡΟΥΡΓΟΣ ΟΥΡΟΛΟΓΟΣ - ΑΝΔΡΟΛΟΓΟΣ
Dr. Πέτρος Σούσσης
Σας καλωσορίζω στον διαδικτυακό μου χώρο, όπου μπορείτε να ενημερώνεστε για όλες τις υπηρεσίες χειρουργικής ουρολογίας και ανδρολογίας που παρέχονται στα ιατρεία μου.
Βασικός μου στόχος η έγκυρη ενημέρωσή σας στα προβλήματα υγείας που σας απασχολούν.
Η πολυετής εμπειρία μου στην υπηρεσία του ασθενούς με δίδαξε ότι όλα τα συμπτώματα πρέπει να τα θεωρούμε σοβαρά αλλά όχι τραγικά.
Μέλος Ιατρικού Συλλόγου Αθηνών
Πολυετή Χειρουργική Εμπειρία
5000+ Ικανοποιημένοι Ασθενείς
Εξειδικεύσεις / Τομείς Ενασχόλησης
Ο ιατρός εξειδικεύεται στη διάγνωση και θεραπεία ουρολογικών και ανδρολογικών παθήσεων, εφαρμόζοντας σύγχρονες και αποτελεσματικές μεθόδους.
- Προστατολογία & καλοήθης υπερπλασία προστάτη
- Λιθίαση ουροποιητικού
- Καρκίνος ουροποιητικού (νεφρός, ουροδόχος κύστη, ουρήθρα)
- Στυτική δυσλειτουργία & ανδρική υπογονιμότητα
- Ουρολοιμώξεις & χρόνιες φλεγμονές
- Ακράτεια ούρων
- Ελάχιστα επεμβατικές / Λαπαροσκοπικές τεχνικές
Εμπειρία
Ο Δρ. Πέτρος Σούσσης διαθέτει πολυετή χειρουργική εμπειρία σε κορυφαία νοσοκομεία και ιδιωτικά ιατρεία, αντιμετωπίζοντας καθημερινά τόσο απλά όσο και σύνθετα ουρολογικά και ανδρολογικά περιστατικά. Η εκτεταμένη κλινική του δραστηριότητα σε συνδυασμό με την συνεχή επιστημονική ενημέρωση του επιτρέπει να εφαρμόζει σύγχρονες, ελάχιστα επεμβατικές τεχνικές, διασφαλίζοντας την ασφάλεια και την υψηλή ποιότητα φροντίδας για κάθε ασθενή.
Με την εμπειρία του, ο Δρ. Σούσσης συνδυάζει ακρίβεια στη διάγνωση, αποτελεσματικότητα στις θεραπείες και προσωπική φροντίδα, προσφέροντας ολοκληρωμένες λύσεις σε κάθε ανάγκη υγείας του ουροποιητικού συστήματος.
ΕΝΗΜΕΡΩΣΗ
Ενημερωθείτε για την σύγχρονη Aνδρολογία
- ΒΡΑΧΥΣ ΧΑΛΙΝΟΣ
- ΠΕΡΙΤΟΜΗ
- ΜΕΓΕΘΥΣΗ ΠΕΟΥΣ ΜΕ ΥΑΛΟΥΡΟΝΙΚΟ ΟΞΥ
- ΥΑΛΟΥΡΟΝΙΚΟ ΟΞΥ ΒΑΛΑΝΟΥ

Τι είναι ο βραχύς χαλινός
Χαλινός ονομάζεται η ελαστική λωρίδα δέρματος που συνδέει την ακροποσθία με την βάλανο.
Συνήθως είναι αρκετά μεγάλος και ελαστικός ώστε να αποκαλύπτεται η βάλανος κατά την στύση του πέους.
Πότε γίνεται η επέμβαση;
- Όταν είναι κοντός και μη ελαστικός , λέγεται βραχύς .Σε αυτή την περίπτωση περιορίζει την κίνηση
- Ρήξη χαλινού κατά την διάρκεια της σεξουαλικής δραστηριότητας με έντονη αιμορραγία και πόνο
- Δυσκολία στην σεξουλιακή διείσδυση
- Επώδυνη σεξουαλική επαφή
- Λοιμώξεις και βαλανοποσθίτιδες
Που γίνεται;
Η επέμβαση γίνεται στο ιατρείο , διαρκεί 10-15 λεπτά με χρήση LASER και τοπική αναισθησία.
Μπορεί να χρειαστεί σε κάποιες περιπτώσεις να εφαρμοστούν
απορροφήσιμα ράμματα που πέφτουν μόνα τους σε 10-15 ημέρες.
ΑΝΑΡΡΩΣΗ
Η σεξουαλική επαφή επιτρέπεται μετά από 2 εβδομάδες που έχει επέλθει η επούλωση.

Τι είναι η περιτομή;
Η περιτομή είναι μια απλή χειρουργική πράξη κατά την οποία αφαιρείται η ακροποσθία, δηλαδή το δέρμα που καλύπτει τη βάλανο του πέους.
Παρακάτω οι λόγοι για τους οποίους πραγματοποιείται:
Επαναλαμβανόμενες φλεγμονές (βαλανίτιδες, βαλανοποσθίτιδες)
Στενότητα ακροποσθίας (φίμωση)
Δυσκολία στην ούρηση
Υποτροπιάζουσες λοιμώξεις
Υγιεινολογικοί ή αισθητικοί λόγοι
Πώς και πού γίνεται;
Η επέμβαση πραγματοποιείται στο ιατρείο ή σε κλινική, με σύγχρονες, ασφαλείς τεχνικές και διαρκεί περίπου 20–30 λεπτά.
Αναισθησία:
Γίνεται με τοπική ή ελαφρά μέθη, ώστε ο ασθενής να μην αισθανθεί πόνο.
Αποθεραπεία:
Η ανάρρωση είναι γρήγορη· ο ασθενής επιστρέφει στις καθημερινές του δραστηριότητες άμεσα, ενώ η πλήρης επούλωση ολοκληρώνεται μέσα σε λίγες εβδομάδες.

Η χρήση του υαλουρονικού οξέος στο πέος είναι μια σύγχρονη τεχνική με θετικά μόνο αποτελέσματα.
Η εφαρμογή υαλουρονικού οξέος στο πέος βοηθά στη βελτίωση της εμφάνισης (μεγέθυνση και πάχυνση), στην αύξηση της αυτοπεποίθησης του άνδρα και, κατ’ επέκταση, στη βελτίωση της σεξουαλικής ζωής. Το μέγεθος επηρεάζει όχι μόνο τον οπτικό ερεθισμό, αλλά και την ικανοποίηση του συντρόφου, καθώς η μεγαλύτερη διείσδυση ενεργοποιεί περισσότερες νευρικές απολήξεις.
Το υαλουρονικό οξύ είναι φυσικό συστατικό του ανθρώπινου οργανισμού, βρίσκεται στον συνδετικό ιστό και στο δέρμα, και λόγω της φύσης του η εφαρμογή μπορεί να επαναληφθεί. Μελέτες δείχνουν ότι μετά από ορισμένες εφαρμογές, το αποτέλεσμα μπορεί να γίνει μόνιμο.
Υπάρχουν διάφοροι τύποι υαλουρονικού οξέος, που διαφέρουν ως προς τη διάρκεια, τη σταθερότητα και το κόστος. Στο ιατρείο μας επιλέγουμε τα καλύτερα υλικά, ενώ η εφαρμογή γίνεται με τοπική αναισθησία και μόνο από τον Dr. Πέτρο Σούσση, ειδικό στην συγκεκριμένη διαδικασία.
Η διάρκεια του υαλουρονικού οξέος μπορεί να φτάσει έως 18 μήνες, με μεγέθυνση 25–40% σε σχέση με το αρχικό μέγεθος. Η διαδικασία είναι ανώδυνη, γρήγορη, και επιτρέπει άμεση επιστροφή στις καθημερινές δραστηριότητες με το βέλτιστο αισθητικό αποτέλεσμα.

Τι είναι η έγχυση υαλουρονικού οξέος στη βάλανο;
Η έγχυση υαλουρονικού οξέος στη βάλανο είναι μια σύγχρονη αισθητική διαδικασία που στοχεύει στη βελτίωση της εμφάνισης και του μεγέθους του πέους.
Σκοπός:
Αύξηση πάχους και μεγέθους
Βελτίωση αισθητικής εμφάνισης
Αύξηση αυτοπεποίθησης και βελτίωση σεξουαλικής ζωής
Πώς γίνεται;
Η εφαρμογή πραγματοποιείται στο ιατρείο με τοπική αναισθησία, χρησιμοποιώντας εξειδικευμένα υλικά και τεχνική από έμπειρο ιατρό.
Διάρκεια αποτελέσματος:
Το αποτέλεσμα διαρκεί έως 18 μήνες, ενώ η διαδικασία είναι ανώδυνη και επιτρέπει άμεση επιστροφή στις καθημερινές δραστηριότητες.
ΕΝΗΜΕΡΩΣΗ
Ενημερωθείτε για την σύγχρονη Γυναικοουρολογία
- ΟΥΡΟΛΟΙΜΩΞΕΙΣ
- ΑΚΡΑΤΕΙΑ
- ΥΑΛΟΥΡΟΝΙΚΟ ΟΞΥ ΟΥΡΟΔΟΧΟΥ ΚΥΣΤΗΣ
- ΚΥΣΤΕΟΣΚΟΠΗΣΗ

Τι είναι οι ουρολοιμώξεις στις γυναίκες;
Οι ουρολοιμώξεις είναι φλεγμονές του ουροποιητικού συστήματος που προκαλούνται κυρίως από μικρόβια, όπως το E. coli. Είναι πολύ συχνές στις γυναίκες λόγω της μικρότερης ουρήθρας.
Συμπτώματα:
Τσούξιμο ή πόνος κατά την ούρηση
Συχνουρία ή αίσθημα ότι δεν αδειάζει πλήρως η κύστη
Θολά ή δύσοσμα ούρα
Πόνος χαμηλά στην κοιλιά
Πώς γίνεται η διάγνωση;
Με γενική και καλλιέργεια ούρων που δείχνουν την παρουσία μικροβίων.
Θεραπεία:
Αφορά χορήγηση αντιβιοτικών και αυξημένη πρόσληψη υγρών. Σε υποτροπιάζουσες περιπτώσεις, ο γιατρός διερευνά πιθανές αιτίες και προτείνει προληπτική αγωγή.
Αποθεραπεία:
Τα συμπτώματα υποχωρούν μέσα σε λίγες ημέρες με τη σωστή αγωγή. Συνιστάται καλή υγιεινή και αποφυγή ερεθιστικών ουσιών στην περιοχή.

Τι είναι η ακράτεια ούρων στις γυναίκες;
Η ακράτεια ούρων είναι η ανεξέλεγκτη απώλεια ούρων, η οποία μπορεί να συμβαίνει κατά την προσπάθεια, το γέλιο, τον βήχα ή ακόμα και χωρίς προφανή αιτία.
Συμπτώματα:
Ακούσια διαρροή ούρων
Συχνή ανάγκη ούρησης
Αίσθημα επείγουσας ούρησης
Πώς γίνεται η διάγνωση;
Με κλινική εξέταση, ιστορικό και ειδικές ουροδυναμικές εξετάσεις.
Θεραπεία:
Μπορεί να περιλαμβάνει ασκήσεις πυελικού εδάφους, φαρμακευτική αγωγή ή επεμβατικές μεθόδους ανάλογα με τον τύπο και τη σοβαρότητα.
Αποθεραπεία:
Με τη σωστή αγωγή και παρακολούθηση, η κατάσταση βελτιώνεται σημαντικά, ενώ η καθημερινότητα της γυναίκας επανέρχεται φυσιολογικά.

Πότε γίνεται το υαλουρονικό στην ουροδόχο κύστη;
Οι ενδοκυστικές εγχύσεις υαλουρονικού οξέως γίνονται σε ασθενείς με διάμεση και χρόνιες κυστίτιδες.
Πως λειτουργεί;
- Το υαλουρονικό οξύ βοηθά στην επούλωση του βλεννογόνου της κύστης
- Δημιουργεί φυσικό φραγμό που προστατεύει την κύστη
- Ανακοφίζει από τα ενοχλητικά συμπτώματα της κύστης
Πως γίνεται;
Η έγχυση γίνεται μέσω λεπτού καθετήρα απευθείας στην κύστη από εξειδικευμένο ιατρό.
Η θεραπεία περιλαμβάνει συνεδρίες κατά τακτά χρονικά διαστήματα ανάλογα με την περίπτωση.

Τι είναι η κυστεοσκόπηση;
Διαγνωστική εξέταση που ο ουρολόγος με ένα λεπτό εργαλείο ( κυστεοσκόπιο) εξετάζει το εσωτερικό της ουρήθρας και της ουροδόχου κύστης .
Παρακάτω οι λόγοι:
- Αιματουρια μικροσκοπική ή μακροσκοπική
- Δυσουρία:δυσχέρεια ούρησης
- Επίμονος πόνος στην κύστη χωρίς ανεύρεση προφανής αιτίας
- Υποτροπιάζουσες ουρολοιμώξεις
- Στενώματα Ουρηθρας
- Υπερπλασία του προστάτη
- Αιμοσπερμία
- Θηλώματα κύστης
- Έλεγχος HPV (κονδυλώματα) ουρήθρας
Πως και που γίνεται;
Στο ιατρείο χωρίς καμία προετοιμασία.χρησιμοποιείται ένα λεπτό σύγχρονο εύκαμπτο ενδοσκόπιο με κάμερα
Αναισθησία;
Γίνεται με τοπική αναισθησία για να είναι ανώδυνη η εξέταση
Αποθεραπεία:
Ο ασθενής τελειώνοντας την εξέταση μπορεί να επιστρέψει άμεσα στις δραστηριότητες του
ΕΞΕΙΔΙΚΕΥΣΕΙΣ-ΕΠΕΜΒΑΣΕΙΣ
Ουρολογικές Επεμβάσεις
ΣΜΝ
Σεξουαλικώς Μεταδιδόμενα Νοσήματα
Τα Σεξουαλικώς Μεταδιδόμενα Νοσήματα είναι λοιμώξεις που μεταδίδονται κυρίως μέσω σεξουαλικής επαφής. Η έγκαιρη διάγνωση και θεραπεία είναι καθοριστικής σημασίας για την προστασία της υγείας και την πρόληψη επιπλοκών. Η πρόληψη περιλαμβάνει ασφαλείς σεξουαλικές πρακτικές, χρήση προφυλακτικού και τακτικούς ελέγχους.
ΑΞΙΟΛΟΓΗΣΕΙΣ ΑΣΘΕΝΩΝ